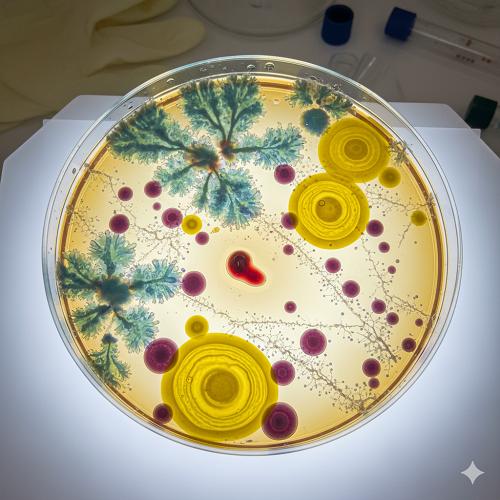

Press release
Latin America Microbiology Culture Market to hit US$ 1,426.75 million by 2033 | Top Companies 2025 - Merck KGaA, CONDALAB, Yokogawa Electric Corporation
"The Latin America microbiology culture market reached US$ 910.94 million in 2024 and is expected to reach US$ 1,426.75 million by 2033, growing at a CAGR of 5.2% during the forecast period 2025-2033." As per DataM intelligence research reportDownload your exclusive sample report today: (corporate email gets priority access): https://www.datamintelligence.com/download-sample/latin-america-microbiology-culture-market?sp
Latin America
Recent Launches and Investments
✅ In July 2025, Thermo Fisher Scientific launched a new line of microbiology culture media in Brazil targeting clinical and research laboratories. The products are designed for high reliability and reproducibility. They support diagnostics and scientific research across Latin America.
✅ In March 2025, BD (Becton Dickinson) expanded its microbiology culture portfolio in Mexico with advanced media formulations. The investment focuses on automation-friendly and rapid diagnostic applications. It aims to enhance laboratory efficiency and accuracy.
Mergers and Acquisitions
✅ In August 2025, Merck KGaA acquired a Latin American microbiology culture manufacturer to strengthen its regional presence. The acquisition enhances production capabilities and supply chain reliability. It supports growth in clinical and industrial microbiology markets.
✅ In May 2025, bioMérieux partnered with a local Latin American supplier to co-develop innovative microbiology culture solutions. The collaboration focuses on quality, consistency, and regulatory compliance. It targets hospitals, diagnostic labs, and research centers.
Latin America Microbiology Culture Market: Drivers
The microbiology culture market in Latin America is experiencing steady growth as healthcare, pharmaceuticals, and research institutions increasingly focus on accurate diagnostics, disease prevention, and drug development. Rising prevalence of infectious diseases, growing demand for rapid pathogen detection, and expanding clinical laboratories are driving adoption of microbiology culture media, reagents, and equipment. Innovations in automated culture systems, ready-to-use media, and high-throughput testing are enhancing efficiency, accuracy, and laboratory productivity. With increasing government initiatives to strengthen healthcare infrastructure and diagnostic capabilities, microbiology culture products are becoming essential tools across hospitals, research centers, and diagnostic labs in the region.
Technological advancements in selective, differential, and enriched culture media are improving pathogen identification, antibiotic susceptibility testing, and research outcomes. Expansion of biotechnology, academic research, and clinical diagnostics sectors is increasing accessibility and market reach. Marketing campaigns emphasizing accuracy, reliability, and ease-of-use are boosting awareness and adoption among laboratory professionals. Rising demand for rapid, cost-effective, and standardized microbiology solutions is driving innovation and product diversification. As healthcare modernization and diagnostic capabilities continue to grow in Latin America, the microbiology culture market is poised for sustained growth and long-term adoption.
Get Customization in the report as per your requirements: https://www.datamintelligence.com/customize/latin-america-microbiology-culture-market?sp
Latin America Microbiology Culture Market: Major Players
Merck KGaA, CONDALAB, Yokogawa Electric Corporation, Kerry Group plc., Sartorius AG, Thermo Fisher Scientific, Inc., and BD among others.
Segment Covered in the Latin America Microbiology Culture Market:
➥ By Product Type: Culture Equipment, Culture Supplements, Measuring Instruments, Culture Instruments, Analytical Devices
➥ By Culture Type: Eukaryotic Culture, Bacterial Culture
➥ By Consistency: Liquid Media, Solid Culture Media, Semi-Solid Media
➥ By Application: Pharmaceuticals, Food & Beverage Industry, Water Testing, Cosmetics
Research Process:
Both primary and secondary data sources have been used in the 55 Market research report. During the research process, a wide range of industry-affecting factors are examined, including governmental regulations, market conditions, competitive levels, historical data, market situation, technological advancements, upcoming developments, in related businesses, as well as market volatility, prospects, potential barriers, and challenges.
Most Frequently Asked Questions in the Latin America Microbiology Culture Market Research Industry:
➠ Who leads the Latin America Microbiology Culture industry and what's their competitive positioning regarding capacity, performance, and profitability?
➠ What growth opportunities and market challenges do Latin America Microbiology Culture market vendors face?
➠ Which segments show the highest growth potential and market share distribution?
➠ What factors are driving or limiting Latin America Microbiology Culture market growth?
➠ What are the dominant sales and distribution strategies in the Latin America Microbiology Culture industry?
Buy Now & Unlock 360° Market Intelligence: https://www.datamintelligence.com/buy-now-page?report=latin-america-microbiology-culture-market
Regional Analysis:
⇥ North America (U.S., Canada, Mexico)
⇥ Europe (U.K., Italy, Germany, Russia, France, Spain, The Netherlands and Rest of Europe)
⇥ Asia-Pacific (India, Japan, China, South Korea, Australia, Indonesia Rest of Asia Pacific)
⇥ South America (Colombia, Brazil, Argentina, Rest of South America)
⇥ Middle East & Africa (Saudi Arabia, U.A.E., South Africa, Rest of Middle East & Africa)
Request for 2 Days FREE Trial Access:
https://www.datamintelligence.com/reports-subscription?sp
✅ Competitive Landscape
✅ Technology Roadmap Analysis
✅ Sustainability Impact Analysis
✅ KOL / Stakeholder Insights
✅ Consumer Behavior & Demand Analysis
✅ Import-Export Data Monitoring
✅ Live Market & Pricing Trends
Have a look at our Subscription Dashboard:
https://www.youtube.com/watch?v=x5oEiqEqTWg
Contact Us -
Company Name: DataM Intelligence
Contact Person: Sai Kiran
Email: Sai.k@datamintelligence.com
Phone: +1 877 441 4866
Website: https://www.datamintelligence.com
About Us -
DataM Intelligence is a Market Research and Consulting firm that provides end-to-end business solutions to organizations from Research to Consulting. We, at DataM Intelligence, leverage our top trademark trends, insights and developments to emancipate swift and astute solutions to clients like you. We encompass a multitude of syndicate reports and customized reports with a robust methodology.
Our research database features countless statistics and in-depth analyses across a wide range of 6300+ reports in 40+ domains creating business solutions for more than 200+ companies across 50+ countries; catering to the key business research needs that influence the growth trajectory of our vast clientele.
This release was published on openPR.
Permanent link to this press release:
Copy
Please set a link in the press area of your homepage to this press release on openPR. openPR disclaims liability for any content contained in this release.
You can edit or delete your press release Latin America Microbiology Culture Market to hit US$ 1,426.75 million by 2033 | Top Companies 2025 - Merck KGaA, CONDALAB, Yokogawa Electric Corporation here
News-ID: 4179185 • Views: …
More Releases from DataM intelligence 4 Market Research LLP
United States Silk Market to Grow at 3.2% CAGR Through 2031 | Asia-Pacific Leads …
Market Overview
The Global Silk Market is projected to grow at a CAGR of 3.2% during the forecast period 2024-2031. Mulberry silk dominates global production, accounting for the majority of commercially produced silk, with governments promoting its cultivation to meet rising demand. While China remains the largest silk producer, India's climatic conditions are particularly favorable for mulberry silk cultivation, offering significant growth potential.
Get a Free Sample PDF Of This Report (Get…
Sericulture Market to Reach USD 468.4 Billion by 2031 | CAGR 8.1% | Asia-Pacific …
Sericulture Market Overview
The Global Sericulture Market reached US$ 251.2 billion in 2022 and is projected to reach US$ 468.4 billion by 2031, growing at a CAGR of 8.1% during the forecast period 2024-2031. Traditionally focused on textiles, the sericulture market is witnessing significant product diversification, with silk being used in cosmetics, medical devices, and industrial applications. This expansion beyond conventional fabrics is a key trend supporting market growth, as it…
Advanced Carbon Materials Market to Reach USD 26.8 Billion by 2031 | CAGR 8.8% | …
Advanced Carbon Materials Market Overview
The Global Advanced Carbon Materials Market reached US$ 15.9 billion in 2023 and is projected to reach US$ 26.8 billion by 2031, growing at a CAGR of 8.8% during the forecast period 2024-2031. Advanced carbon materials such as graphite, carbon fiber, carbon nanotubes, graphene, and diamond are widely used across multiple industries due to their exceptional mechanical strength, stiffness, thermal stability, and low density. Their superior…
High Early Strength Cement (HE) Market to Reach USD 2.3 Billion by 2031 | CAGR 4 …
Market Size & Overview
The Global High Early Strength Cement (HE) Market reached US$ 1.5 billion in 2022 and is projected to reach US$ 2.3 billion by 2031, growing at a CAGR of 4.7% during the forecast period 2024-2031. High early strength cement is a specialized cement variant designed to achieve faster setting and early strength development, making it ideal for projects requiring quick construction or maintenance. It is extensively used…
More Releases for America
Stabilit America Highlights Applications of Fiberglass Roof Panels with Stabilit …
Roofing materials are very important in the realm of modern construction, as they should be long lasting, economical and attractive. Fiberglass roof panels are a few of the numerous choices among several alternatives that have received a reputation of being versatile, long life, and adaptable in various sectors. They are favored by the architects, contractors, and property developers due to their lightweight construction, resistance to weather factors, and the ease…
Deodorants Market Report by Region (North America, EMEA, Latin America, Asia)
2025 - Pristine Market Insights, a leading market research firm, announced the release of its latest and comprehensive market research report on Deodorants market. The report spans over 500 pages and delivers 10-year market forecast in US dollars (or custom currencies upon request). It provides in-depth analysis of market dynamics (drivers, opportunities, restraints), PESTLE insights, latest industry trends, and demand factors. The report includes segmented market value, share (%), compound…
Sequestrant Market Report by Region (North America, EMEA, Latin America, Asia)
2025 - Pristine Market Insights, a leading market research firm, announced the release of its latest and comprehensive market research report on Sequestrant market. The report spans over 500 pages and delivers 10-year market forecast in US dollars (or custom currencies upon request). It provides in-depth analysis of market dynamics (drivers, opportunities, restraints), PESTLE insights, latest industry trends, and demand factors. The report includes segmented market value, share (%), compound…
Buttermilk Market Study by Region (North America, Latin America, Europe, Asia, M …
2025 - Pristine Market Insights, a leading market research firm, announced the release of its latest and comprehensive market research report on Buttermilk market. The report spans over 500 pages and delivers 10-year market forecast in US dollars (or custom currencies upon request). It provides in-depth analysis of market dynamics (drivers, opportunities, restraints), PESTLE insights, latest industry trends, and demand factors. The report includes segmented market value, share (%),…
Textiles Market Analysis Report, Regional Outlook - Europe, North America, South …
Adroit Market Research has announced the addition of the “Global Textiles Market Size Status and Forecast 2025”, The report classifies the global Textiles in a precise manner to offer detailed insights about the aspects responsible for augmenting as well as restraining market growth.
This report studies the global Textiles Speaker market, analyzes and researches the Textiles Speaker development status and forecast in Europe, North America, Central America, South America, Asia Pacific…
Global Gaucher Disease Market 2018 Covering North America, South America, Europe
Gaucher Disease Market
Summary
The Global Gaucher Disease Market is defined by the presence of some of the leading competitors operating in the market, including the well-established players and new entrants, and the suppliers, vendors, and distributors. The key players are continuously focusing on expanding their geographic reach and broadening their customer base, in order to expand their product portfolio and come up with new advancements.
Gaucher Disease market size to maintain the average annual growth…